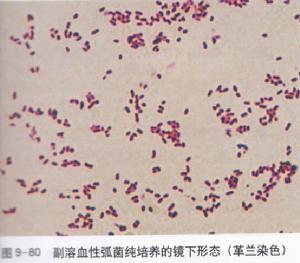
副溶血性弧菌

基本概述
副溶血弧菌是革蘭氏陰性多形態桿菌或稍彎曲弧菌。本菌嗜鹽畏酸,在無鹽培養基上,不能生長,3%~6%食鹽水繁殖迅速,每8~9分鐘為1周期,低於0.5%或高於8%鹽水中停止生長。在食醋中1~3分鐘即死亡,加熱56℃5~10分鐘滅活,在1%鹽酸中5分鐘死亡。
已知副溶血弧菌有12種O抗原及59種K抗原,據其發酵糖類的情況可分為5個類型。各種弧菌對人和動物均有較強的毒力,其致病物質主要有分子量42000的致熱性溶血素(TDH)和分子量48000的TDH類似溶血毒(TRH),具有溶血活性、腸毒素和致死作用。
 副溶血性弧菌
副溶血性弧菌進食被副溶血性弧菌污染的食物後10小時左右出現上腹部陣發性絞痛、腹瀉,多數患者在腹瀉後出現噁心、嘔吐,腹瀉多為水樣便,重者為黏液便和黏血便。嘔吐、腹瀉嚴重,失水過多者可引起虛脫並伴有血壓下降。大部分病人發病後2~3天恢復正常,少數嚴重病人由於休克、昏迷而死亡。
發現過程
1950年,以日本大阪府為中心的泉州地方,發生了第二次世界大戰以來最嚴重的集體食物中毒事件。患者出現劇烈腹痛及下痢的症狀,原因不明。最後統計共有272名患者中毒,其中有20名死亡。發病的患者全部都食用了大阪府的行商所販賣的青魚乾,因此當局立刻對這批魚乾進行分析。然而,在魚乾中並未發現任何已知會導致食物中毒的細菌。因此,當局懷疑有人刻意將毒物混入魚乾中,將這個事件作為刑事案件調查。
由於前一年的1949年才剛發生了並稱為“日本國鐵三大謎案”的松川事件、下山事件及三鷹事件,在這樣的背景下,導致了民眾的恐慌。有人認為,這起集體食物中毒事件是為了使社會混亂而進行的下毒。然而,在魚乾中並未化驗出包括砒霜、亞硝酸鹽等任何有毒化學物質,事件的原因仍然不明。
對此,大阪大學的藤原恆三郎教授從未知感染菌的角度進行了分析。他使用洋菜培養基培養菌種,並進行動物實驗,最後終於從魚乾樣品中分離了一種新種細菌,即腸炎弧菌,找出了食物中毒的原因。由於這種新種細菌是日本人發現的,在當時的日本醫學界掀起了一陣波瀾。當時大多數的日本學者對病菌的概念,都還停留在19世紀的老舊觀念;腸炎弧菌的發現震撼了他們。發現者藤原教授用“粗大且筆直,不斷的活動”(日文:ふとっちょで真っ直ぐで、よく動き回る)來形容這種細菌的外型。此種病菌與當時弧菌屬的代表霍亂弧菌外型差異甚大,因此藤原認為此菌應歸類為巴斯德菌屬,在1951年將其命名為Pasteurellaparahaemolyticus並發表。
1955年,日本國立橫濱醫院的醫師滝川巖在醃漬物中發現了食物中毒的病原菌,後來證明與大阪中毒事件的病原菌是相同的。同時,他也發現了這種細菌是嗜鹽性的,因此,將此菌的日文名稱定為病原性好鹽菌(日文:病原性好塩菌)。
1960年,日本東京及千葉縣一帶發生了多起因食用竹莢魚而導致食物中毒的事件,檢驗後發現病原菌是腸炎弧菌,引起了醫學界的注意。對此,厚生省(今厚生勞動省,日本中央政府的衛生主管單位)將腸炎弧菌列為引起食物中毒的重要病原菌之一,進行相關研究。
1963年,日本國立預防衛生研究所(今日本國立傳染病研究所)的福見秀雄和坂崎利一證明了此種細菌應屬於弧菌屬,將學名改定為Vibrioparahaemolyticus,同時也將此種細菌的日文名稱改為腸炎弧菌(日文:腸炎ビブリオ),沿用至今。
性狀
 弧菌屬細菌的型態比較 左:霍亂弧菌的模式圖,有弧菌的典型特徵:逗點狀的桿菌本體及粗的單毛性鞭毛(端鞭毛)。 右:腸炎弧菌的形式圖,細菌本體的形狀是筆直的棒狀,除了端鞭毛外,還有許多細的側鞭毛。
弧菌屬細菌的型態比較 左:霍亂弧菌的模式圖,有弧菌的典型特徵:逗點狀的桿菌本體及粗的單毛性鞭毛(端鞭毛)。 右:腸炎弧菌的形式圖,細菌本體的形狀是筆直的棒狀,除了端鞭毛外,還有許多細的側鞭毛。腸炎弧菌和霍亂弧菌、創傷弧菌等細菌,都是弧菌科弧菌屬的成員。但是,腸炎弧菌和其他弧菌在一些特徵上,有著相當的不同。腸炎弧菌的長度約是0.3×2µm,其細菌本體不像典型弧菌的彎曲狀,反而是筆直的棒狀(類似桿菌)。此外,腸炎弧菌不能使乳糖及蔗糖發酵,與可以發酵葡萄糖及蔗糖的其他弧菌科細菌不同,這也是區別腸炎弧菌與其他弧菌的方法之一。由於這個特性,腸炎弧菌在tcbs培養基上呈現亮綠色,與一般弧菌的黃色不同。
腸炎弧菌對酸鹼改變敏感,適合生長的pH值約在7.5-8之間,可耐受的酸鹼值為pH5-11。腸炎弧菌與霍亂弧菌相同,都喜歡偏鹼性的環境,但是與霍亂弧菌不同的是,腸炎弧菌必須要在環境有氯化鈉存在的條件下才能增殖(但是如果使用血液洋菜膠培養基時則不需要添加氯化鈉)。適合腸炎弧菌生長的鹽度約在2-3%,超過10%或低於0.5%均不能增殖。
適合腸炎弧菌生長的溫度約在20℃以上,溫度在15℃以下時,生長會受到抑制。腸炎弧菌對熱的耐受力相當低,使用一般的高溫滅菌法即可完成殺菌。因此,因腸炎弧菌而造成食物中毒的患者,通常是肇因於食用未經煮熟的海產。此外,腸炎弧菌菌株在低溫時也容易死亡。腸炎弧菌不耐乾燥(aw=0.948時無法生長),在乾燥環境中會迅速死亡。
腸炎弧菌的增殖速度很快,在含3%氯化鈉的腦心浸出物培養液中,只要8分鐘左右就會分裂一次。而該菌在海產中的繁殖也相當迅速,例如:30℃時,腸炎弧菌在章魚中從102CFU/g繁殖到107CFU/g僅需六小時。腸炎弧菌的增殖迅速是造成食物中毒的一大原因。
腸炎弧菌擁有一大一小的兩個染色體(分別有3.2×106和1.9×106個鹼基對),是人類首次發現擁有複數染色體的細菌品種。
生物學特性
(1)形態染色:
革蘭陰性菌,隨培養基不同菌體形態差異較大,有卵圓形、棒狀、球桿狀、梨狀、弧形等多種形態。兩極濃染。菌體一端有單鞭毛,運動活潑。無芽胞、無莢膜。
(2)培養特性:
需氧,營養要求不高,在普通培養基中加入適量NaCl即能生長。NaCl最適濃度為35g/L,在無鹽培養基中不生長。本菌不耐熱,不耐冷,不耐酸,對常用消毒劑抵抗力弱。生長所需pH為7.0~9.5,最適pH為7.7.
在液體培養基表面形成菌膜。
在35g/LNaCl瓊脂平板上呈蔓延生長,菌落邊緣不整齊,凸起、光滑濕潤,不透明;
在副溶血性弧菌專用選擇培養基上形成1~2.5mm,稍隆起、混濁、無粘性、綠色菌落;
在SS平板上不生長或長出1~2mm扁平無色半透明的菌落,不易挑起,挑起時呈粘絲狀醫學教`育網蒐集整理。
在羊血瓊脂平板上,形成2~3mm、圓形、隆起、濕潤、灰白色菌落,某些菌株可形成β溶血或α溶血。
在TCBS瓊脂上不發酵蔗糖,菌落綠色。(與霍亂弧菌相區別)
(3)生化反應:
本菌在30g/LNaCl和70g/LNaCl培養基中生長,在無鹽或100g/LNaCl培養基中不生長。神奈川試驗是致病菌株能使人或兔紅細胞發生溶血,對馬紅細胞不溶血,稱神奈川試驗陽性。
微生物學檢驗
1)標本採集:
主要是患者的糞便、可疑食物、炊事用具的洗滌液等醫學教育網蒐集整理。
2)檢驗方法及鑑定:
(1)增菌培養:取標本0.5~1ml接種40g/LNaCl蛋白腖水中,37℃培養,若有本菌存在,一般數小時即出現明顯混濁,即可分離培養.
②分離培養:將標本或增菌培養物接種副溶血弧菌選擇培養基35℃培養18~24h觀察結果。菌落濕潤、混濁無粘性,呈綠色;
③鑑定:根據其形態、染色、多形性、活潑動力等特點,以及在選擇培養基上的菌落特徵,結合氧化酶試驗陽性,在KIA上K/A,H2S(-)。在MIU上“++-”。以及嗜鹽試驗和血清學分型可作初步鑑定。
最後鑑定,必要時作進一步生化試驗及毒力試驗。
3.臨床意義:
致病因子有粘附因子(主要為菌毛)、毒素(如耐熱性溶血素)。
所致疾病為食物中毒及急性胃腸炎,常為被污染的海產品及鹽醃製品所引起,此菌尚可引起淺表創傷感染、敗血症等。
4.治療原則:
選用合適的抗生素及其他抗菌藥物,嚴重病例需輸液及補充電解質。
中毒預防
 副溶血性弧菌
副溶血性弧菌輔助檢查:
1、白細胞計數總數多在1萬mm3以上,中性粒細胞偏高。
2、便檢查鏡檢可見白細胞或膿細胞,常伴有紅細胞,易被誤診為菌痢。糞便培養可檢出副溶血弧菌,絕大多數迅速轉陰,僅少數持續陽性2~4天。
治療措施
 副溶血性弧菌
副溶血性弧菌1、支持及對症治療脫不者需輸入生理鹽水及葡萄鹽水,或口服補液鹽,以糾正失水。血壓下降者,除被補充知容量,糾正酸中毒等外,可酌用血管活性藥。
2、抗菌藥物輕者患者可不用抗菌藥物,較重者可給複方新諾明或慶大黴素、阿米卡星和諾氟沙星等喹諾酮類抗菌藥物。
3、發生中毒後要立即停止食用可疑中毒食品,併到醫院醫治。副溶血性弧菌對氯黴素敏感。嘔吐、腹瀉嚴重者要補充水和鹽。
發病機理
 副溶血性弧菌
副溶血性弧菌TDH對心臟有特異性心臟毒,可引起心房纖維性顫動、期前收縮或心肌損害。最近有人發現脲酶與本病腹瀉有關。患者體質、免疫力不同,臨床表現輕重不一,呈多型性。山區、內陸居民去沿海地區而感染者病情較重,臨床表現典型;沿海地區發病者病情一般較輕。
流行病學
副溶血性弧菌
副溶血性弧菌2、傳播途徑本病經食物傳播,主要的食物是海產品或鹽醃漬品,常見者為蟹類、烏賊、海蜇、魚、黃泥螺等,其次為蛋品、肉類或蔬菜。進食肉類或蔬菜而致病者,多因食物容器或砧板污染所引起。
3、易感者男女老幼均可患病,但以青壯年為多,病後免疫力不強,可重複感染。本病多發生於夏秋沿海地區,常造成集體發病。近年來沿海地區發病有增多的趨勢。
臨床表現
潛伏期自1小時至4天不等,多數為10小時左右。起病急驟,常有腹痛、腹瀉、嘔吐、失水、畏寒及發熱。腹痛多呈陳發性絞痛,常位於上腹部、臍周或回盲部。腹瀉每日3~20餘次不等,大便性狀多樣,多數為黃水樣或黃糊便。2%~16%呈典型的血水或洗肉水樣便,部分病人的糞便可為膿血樣或粘液血樣,但很少有里急後重。由於吐瀉,患者常有失水現象,重度失水者可伴聲啞和肌痙攣,個別病人血壓下降、面色蒼白或發紺以至意識不清。發熱一般不如菌痢嚴重,但失水則較菌痢多見。近年來國內報導的副溶血弧菌食物中毒,臨床表現不一,可呈典型、胃腸炎型、菌痢型、中毒性休克型或少見的慢性腸炎型。本病病程自1~6日不等,可自限,一般恢復較快。
PCR檢測
用於檢測該菌的PCR方法主要有任意引物PCR(abritrarilyprimedPCR,Ap-PCR)、針對任意引物PCR、多重PCR(muhiplex-PCR)、實時PCR(Real-timePCR)。1、任意引物PCRMatsumoto等採用任意引物PCR對副溶血性弧菌進行檢測。針對該菌的tdh基因和trh基因一段特異的序列,設計兩條引物,
引物1:5’--GGTGCGGGAA--3’
引物2:5’一GTTTCGCTCC一3’
對1977~1998年所收集的227株副溶血性弧菌進行PCR。通過電泳分析發現,1996~1998年收集的22株血清型為03:K6菌株與1996年以前收集的03:K6血清型菌株基因序列有所不同,為03;K6血清型新出現的變異株,並最初出現在孟加拉國。這是目前最簡單的以基因為基礎的細菌亞分型方法。
2、針對任意引物PCR由於臨床分離株絕大多數含有tdh基因,因此絕大部分研究者都根據tdh設計引物進行特異擴增。1993年,Lee等根據tdh基因設計引物,對36株TDH+株、89株TDH-株以及46株其他弧菌和腸道菌進行PCR檢測。結果顯示,36株TDH+株全部特異擴增出來,其餘菌株都沒有擴增;而檢測靈敏度高,最低檢測量可至40pg DNA,並可直接檢測糞便標本,無需分離培養,方便快速。1999年,Kim等選擇toxR基因序列設計兩對引物,5’--GTCTTCTGACGCAATCGTTG--3’和5’一ATACGAGTGGTTGCTGTCATG一3’,對14株副溶血性弧菌、14株其他弧菌進行PCR。結果顯示,14株副溶血性弧菌都得到一條368bp的特異擴增亮帶,而其他菌株沒有特異擴增。此外,Venkateswaran等選擇gyrB基因設計引物對副溶血性弧菌進行PCR、Cordova等選擇pR72H基因設計引物進行PCR,特異性、靈敏度都很好。
3、多重PCR由於不是全部副溶血性弧菌都含tdh基因或trh基因,所以只針對tdh或trh的單一PCR,有時會漏檢。多重PCR能全方位高效率地檢測該菌。1994年研究人員等針對tdh、trh設計不同的引物對,在同一PCR反應體系內同時擴增tl、tdh、trh。結果顯示,所有的副溶血性弧菌都擴增出tl基因,tl基因是該菌特異的;54%的副溶血性弧菌擴增出tdh基因;只有38.73%的副溶血性弧菌擴增出trh基因;該法靈敏度很高。與其他常規生化方法相比,多重PCR更快速,僅8h就能完成檢測,結果更為準確、可靠,而且還可改進成定量競爭PCR,對標本中靶序列進行定量。
4、實時PCR常規PCR檢測,需要從反應體系中吸取產物做電泳或Southern雜交等試驗進行鑑定,轉移過程中易污染,造成假陽性,而且耗費時間。1996年,Tyagi開創了一種實時PCR(Real-time PCR)。實時PCR是在PCR反應體系中加入標記有報告基團和淬滅基團的線性Taqman探針或莖環型螢光分子信標探針,在基因擴增過程中,與產物雜交,此時,報告基團和淬滅基團分開,根據能量共振轉移現象,報告基團發出螢光而被檢測。這種方法操作簡單,閉管檢測,減少污染,靈敏度高,並且可以在PCR結束或PCR過程進行同步定性或定量檢測,面且可以進行臨床大規模快速檢測。
常見內科疾病1
| 內科疾病治療預防、 |

